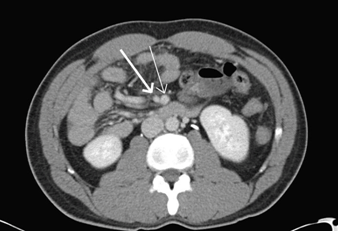

|
 |
|
Clinical Image
| ||||||
| Appendicitis in the setting of undiagnosed non-rotation of the midgut: A case report | ||||||
| Ashraf Tokhi1, Eliza Muir2 | ||||||
|
1MBBS, BmedSci, St Vincents Hospital, Fitzroy VIC Australia 2MBBS, BSc, Austin Hospital, Heidleberg VIC | ||||||
| ||||||
|
[HTML Abstract]
[PDF Full Text]
[Print This Article] [Similar article in Pumed] [Similar article in Google Scholar] 
|
| How to cite this article |
| Tokhi A, Muir E. Appendicitis in the setting of undiagnosed non-rotation of the midgut: A case report. Int J Case Rep Images 2017;8(10):675–677. |
|
CASE REPORT
| ||||||
|
A 32-year-old male presented with a history of three-day left sided abdominal pain. The pain was initially generalized, then later localized to the left iliac fossa with associated fevers, vomiting, anorexia and constipation. Examination elicited generalized peritonism, with rebound tenderness worst in the left iliac fossa, and positive psoas sign. Variation in locality of tenderness and uncertain diagnosis required further investigation; a computed tomography scan of abdomen and pelvis. Imaging demonstrated marked dilatation of the appendix and periappendiceal fat stranding, confirming acute appendicitis (Figure 1). Non-rotation of the midgut was also noted, with the appendix and cecum was located in the left lower quadrant, and the majority of small bowel seen on the right side of abdomen (Figure 2). No bowel obstruction was present. The patient was commenced on intravenous antibiotics and preceded to theatre for emergency appendicectomy. Laparoscopy showed four quadrant peritonitis with a left-sided cecum. The appendix was grossly inflamed with a perforation at the base. The procedure was converted to laparotomy, the appendix was resected and the peritoneal cavity was washed out copiously (Figure 3). No evidence of bowel obstruction was noted. The patient had an uncomplicated postoperative course, and was discharged at postoperative day-10. He remained well at second week follow-up. | ||||||
| ||||||
| ||||||
| ||||||
|
DISCUSSION
| ||||||
|
Intestinal non-rotation is a congenital abnormality resulting from a lack of midgut rotation during the first trimester, and is one of a number of malrotation variations. Malrotation is estimated to occur in one in 500 live births. However, incidental non-rotation has been noted in 0.5% of autopsies [1]. During the fourth to eighth week of embryonic growth, the midgut exits the coelom into the yolk sac where its rapid growth can be accommodated. The midgut rotates 90 degrees counterclockwise in the yolk sac. Non-rotation occurs when, after re-entering the abdomen during the eighth to tenth week, the midgut does not continue any additional rotation. This results in a left sided colon and predominantly right sided small bowel. It is hypothesized that this is due to laxity of the umbilical ring, resulting in an early reduction of the colon and cecum [2]. Generally, there are three different presentations of non-rotation pathology; acute obstruction, chronic intermittent obstruction, and as an incidental finding [3]. Almost 60% of individuals with any gut malrotation will present with an acute obstruction secondary to volvulus by their first birthday [4]. In the adulthood only 12% of presentations relating to malrotation are secondary to volvulus [5]. The more common presentation is chronic obstruction, with symptoms of non-specific abdominal pain, intermittent nausea and vomiting. Contrary to traditional teaching, nearly half of patients with midgut non-rotation present symptomatically in adulthood [5][6]. Infrequently, such as in our case, midgut non-rotation is observed as an incidental finding for investigation of other conditions [3][7]. The presence of non-rotation is important when considering surgical intervention, due to the variant anatomy. In our situation, laparoscopic access was obtained with port insertion into the suprapubic area and the right low quadrant over McBurney’s point. This provided adequate access to the appendix and cecum, now located in the left lower quadrant. Whilst surgical intervention in the form of a Ladd’s procedure has been suggested for symptomatic non-rotation, major guidelines recommend that in asymptomatic patients, a conservative approach is followed, with an emphasis to the patient to present early if any symptoms occur in the future [8]. | ||||||
|
CONCLUSION
| ||||||
|
As was noted in this case, patients with midgut non-rotation can present a diagnostic dilemma, due to the disparity in location of abdominal viscera, and thus variation in symptomatology. Delay in diagnosis and treatment can have severe consequences, and thus it is important to consider early radiographic investigation for further evaluation. In line with guidelines, we do not recommend surgical intervention in asymptomatic patients, but encourage early presentation if any abdominal symptoms occur in the future. Keywords: Appendicitis, Malrotation, Non-rotation | ||||||
|
REFERENCES
| ||||||
| ||||||
|
[HTML Abstract]
[PDF Full Text]
|
|
Acknowledgements
We are thankful to Dr Leah Marley MBBS, Mr Fred Huynh MBBS FRACS, and Mr Niruben Rajasagaram MBBS FRACS for their generous assistance in preparing this report. |
|
Author Contributions
Ashraf Tokhi – Substantial contributions to conception and design, Acquisition of data, Drafting the article, Final approval of the version to be published Eliza Muir – Substantial contributions to conception and design, Analysis and interpretation of data, Drafting the article, Revising it critically for important intellectual content, Final approval of the version to be published |
|
Guarantor
The corresponding author is the guarantor of submission. |
|
Source of support
None |
|
Conflict of interest
Authors declare no conflict of interest. |
|
Copyright
© 2017 Ashraf Tokhi et al. This article is distributed under the terms of Creative Commons Attribution License which permits unrestricted use, distribution and reproduction in any medium provided the original author(s) and original publisher are properly credited. Please see the copyright policy on the journal website for more information. |
|
|